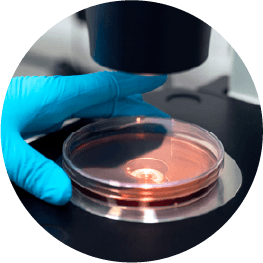

THE HIVE IMMUNE SYSTEM
蜂窩的世界
Beehive World
蜂膠 (Propolis) 是蜜蜂從花蕾中採集的一種樹脂物質,加上外部滲出的蠟狀分泌物,用於保護蜂巢免受寄生蟲侵害。
A COMPLEX COMPOSITION…
蜂膠內容物非常複雜
蜂膠的成分是一種複合物,含樹脂 (50%)、蠟狀物 (30%)、精油 (10%)、花粉 (5%)及其他有機活性成分 (5%) 包括多種多酚物質。
… AND A HIGH VARIABILITY
蜂膠效性成分多樣化
要做到標準化
是非常困難的挑戰
由於來源、氣候條件、地理位置、植物生態、季節、蜜蜂種類等的差異,蜂膠的活性成分組成是非常的複雜的,要達成穩定的活性成分組成是一項艱鉅的挑戰!
FROM PROPOLIS TO PROPOLIS M.E.D.™ 從傳統走向科技
傳統的蜂膠萃取方法只使用酒精,雖可萃取出高濃度的多酚,但沒有選擇性,無法汰弱留強。

THE CORE BIOACTIVES OF PROPOLIS M.E.D.™ : POLYPHENOLS
More than 300 polyphenols have been isolated in propolis. The extract obtained with the patented Multi Dynamic Extraction method contains the integral complex of polyphenols naturally present in propolis and is characterized and standardized by the presence of a biologically active complex including 6 representative polyphenols:

市面上蜂膠商品琳瑯滿目,良莠不齊,真假難辨,選擇有良好信譽的蜂膠供應商,才不會吃虧上當。
有宣稱類黃酮含量高的綠蜂膠,其樣品 HPLC-UV 分析圖譜顯示檞皮素 (QUERCETIN) 含量高的異常,蜂膠其他的類黃酮比例卻極低,也不見綠蜂膠特有的類黃酮 ARTEPILLIN C ,更有趣的是,檞皮素 (QUERCETIN) 並不是天然綠蜂膠的主要類黃酮,含量應該很低。

Fytexia 為了確保產品的有效安全性,對蜂膠原料及所有製程執行最嚴格的控管。
提供蜂膠原料給 Fytexia 的蜂農都必須簽署一份強制性品保技術協議:
自然生態保護及永續經營是這些蜜蜂養殖規範的基礎。
FROM A TRADITIONAL MATERIAL TO A CUTTING-EDGE INGREDIENT
Research program: pipeline of development and scientific investigations
BIOACTIVE COMPOUNDS CHARACTERIZATION
活性成分定性、定量及標準化
專利 M.E.D.™ 萃取方法完整保留蜂膠中的天然活性物質,同時確保再現性及其特性。
IN VITRO INVESTIGATIONS
體外實驗證實 Promunel® 可調整體質、維持絕佳防線
In vitro testing demonstration health promotion of Propolis M.E.D.™
CLINICAL BENEFITS
人體臨床實驗結果發表公開文獻
Human trial investigation on the effect of Propolis M.E.D.™ consumption on the URTIs. Published clinical results.
SUPPORTING STUDIES - Publications: Esposito et. Al. Phytomedicine, 2021 | Galeotti et. Al. Foods, 2018 | Zaccaria et. Al. Nutrients, 2017 | Zaccaria et. Al. Materials, 2019 | Galeotti et. Al. J. Med. Plants Res. 2019 | Curti et. Al. Int. J. Mol. Sci. 2019
大量科學證據佐證: 有效成分及生理利用率、體外實驗、臨床實驗文獻發表
Promunel® 原廠文獻資料庫: https://www.fytexia.com/en/health-areas/immunity-antioxidant-homeostasis/immune-respiratory-health-promunel/

300 MT PRODUCTION CAPACITY
3 DEDICATED PRODUCTION LINES
EXTRACTION LINE
Processing capabilities up to 200 kg/day of raw Propolis with an evaporative capacity of solvent up to 100 liters/hour.
LIQUID LINE
Processing capabilities from 500 to 1000 liters/day.
SPRAY DRIED LINE
Able to dry up to 300 kg/day of propolis mother extract.




COMMERCIAL NAME
註冊商標
Promunel®
Product
產品名稱
Promunel® 蜂膠萃取物
ACTIVE COMPOUNDS
效性成分
標準化蜂膠多酚,主要含 PPN6® 六種類黃酮多酚:Galangin, Apigenin, Quercetin, Pinobanksin, chrysin, Pinocembrin.
RECOMMENDED DOSAGE
建議劑量
12 to 24 mg polyphenol complex / day. 每日 12~24mg (以多酚計)
APPLICATIONS
產品應用
錠劑、膠囊、粉包、軟膠囊、滴劑、噴劑、糖漿、漱口液、牙膏等。
OTHERS
其他特色
無過敏原、非基改、Halal、KOSHER、無麩質、素食。
GRADE
GREIT 120
12mg/ml total polyphenols HPLC-ESI-MS
EPE 38 80 GA
38mg/ml total polyphenols expressed as Galangin UV Folin Ciocalteu - HPLC-ESI-MS
POLE G
30 mg/ml total polyphenols in sunflower oil
CLINICALLY TESTED DOSAGE EQUIVALENT
建議劑量
DELIVERY SYSTEM
劑型
Tablets
錠劑
Capsules
膠囊
Sprays
噴劑
Mouthwashes
漱口水
Toothpastes
牙膏
Tinctures
酊劑
Soft gels
軟膠囊